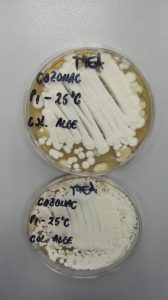

Metaboliții primari sunt aceia care au legatură directă cu procesele fundamentale de supraviețuire ale microorganismului, în timp ce metaboliții secundari acoperă acele componente pentru care încă nu se cunosc funcțiile. Mulți metaboliți secundari au compoziție chimică complexă și mulți sunt extrem de toxici pentru alte forme de viață (antibioticele fac parte din această categorie). În ultimul timp, interesul în izolarea și caracterizarea acestor metaboliți a crescut rapid, motivul fiind apariția micotoxinelor. Acești metaboliți secundari sunt produși, în principal, de următoarele specii de fungi: Aspergillus sp., Penicillium sp., Fusarium sp.
În acest context, prezentul studiu a urmărit stabilirea incidenței apariției mucegaiurilor de alterare ale produselor de panificație, în funcție de tipul de produs și condițiile de depozitare și identificarea lor. De asemenea, a fost urmărită corelarea incidenței apariției micotoxinelor cu gradul de contaminare microbiologică, tipul de mucegaiuri de alterare și condițiile de depozitare ale alimentelor.
La realizarea studiului au fost selectați, în mod aleatoriu, dintr-un centru comercial, cozonaci fabricați de trei producători autohtoni și diferite tipuri de pâine. Controlul microbiologic al unui aliment presupune nu numai cuantificarea încărcăturii microbiene a acestuia, ci şi identificarea speciilor de microorganisme prezente în produs. Astfel, în cazul probelor supuse testării, s-a urmărit identificarea și caracterizarea de tulpini fungice din microbiota de alterare a acestui produs.
Identificarea microorganismului izolat din produsul alimentar studiat, utilizând sistemul Biolog® a descris microorganismul Fusarium graminearum Schwabe BGC (teleo. Gibberella zeae), un patogen al plantelor, responsabil de apariția unor boli devastatoare pentru culturile de grâu și orz.

Mucegaiul izolat de pe suprafața probelor de pâine, respectiv pâine albă, a fost identificat cu ajutorul sistemului Biolog® drept Aspegillus parasiticus, un mucegai cunoscut ca fiind producător de aflatoxine. Aspegillus parasiticus (fig. 3.) face parte din regnul Fungi, încrengătura Ascomycota, clasa Eurotiomycetes, ordinul Eurotiales, familia Trichocomaceae, genul Aspergillus.

Aspegillus parasiticus este un microorganism ubicuitar în natură care a devenit însă o cauză tot mai importantă de apariție a numeroase boli. Acest mucegai este producător de aflatoxine, el înregistrând un nivel ridicat de patogenitate în diverse stadii ale dezvoltării sale. A. parasiticus este una dintre speciile de mucegaiuri responsabile de contaminarea fungică atât în câmp, cât și în timpul recoltării cât și a depozitării. A. parasiticus produce toate cele patru aflatoxine B1, B2, G1, respectiv G2, dintre care aflatoxina B1 este cea mai abundentă și un carcinogen natural cunoscut.
Analiza microbiologică a alimentelor a pus în evidenţă contaminarea microbiologică a probelor selectate pe perioada depozitării şi a indicat incidența apariției mucegaiurilor în funcție de condiţiile de păstrare. Fusarium graminearum, respectiv Aspergillus parasiticus, sunt microorganisme producătoare de micotoxine. Răspândirea diferitelor specii de mucegaiuri este influenţată de încărcătura microbiologică inițială a produsului alimentar, precum și de condiţiile de depozitare. Astfel, există mai mulţi factori care influenţează dezvoltarea mucegaiurilor şi producerea de micotoxine, dintre care cei mai importanți sunt (a) factori externi precum temperatura, umiditatea aerului sau compoziţia aerului, (b) factori interni, ca structura matricei alimentare, conţinutul în substanţe nutritive şi de creştere și (c) factori biologici, dintre care amintim tipul şi gradul de contaminare, acţiuni antagoniste, acţiuni sinergetice.
Micotoxinele sunt rezistente la acţiunea agenţilor chimici şi a tratamentelor termice care distrug sporii. Astfel, o contaminare inițială cu mucegaiuri producătoare de micotoxine a materiilor prime utilizate în producerea alimentelor este deosebit de periculoasă, prin efectele toxice şi cancerigene, cu atât mai mult cu cât acestea rezistă proceselor tehnologice.
Prezentul studiu a fost realizat prin Programul-nucleu, derulat cu sprijinul MCI, contract nr. 29N/2016, proiect PN 16 46 04 02.
Text:
Irina Smeu*, Elena Mirela Cucu, Alina Alexandra Dobre, Enuța Iorga
*Șef colectiv ELISA, laborator Microbiologie-ELISA
Institutul Național de Cercetare-Dezvoltare pentru Bioresurse Alimentare – IBA București
Republicarea conținutului website-ului www.brutarul.ro este permisă în limita de 400 de caractere, cu precizarea sursei și inserarea unui link spre www.brutarul.ro.

